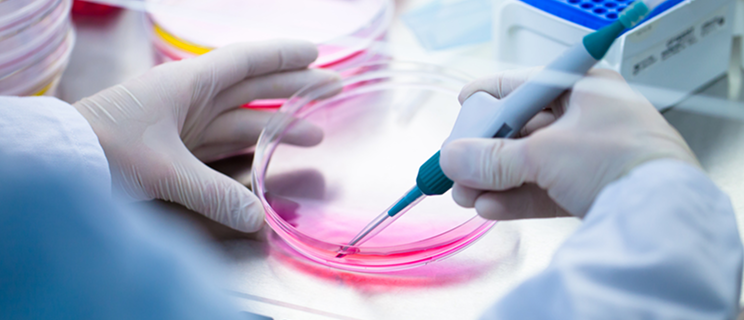

- Home
- ソリューション
- 製薬ソリューション
- Non-Clinical CRO
- 安全性評価
- 遺伝毒性試験
遺伝毒性試験
復帰突然変異試験(Ames試験)での陰性・陽性の判定には、施設独自の背景データとの比較が重要な指標になります。
国内でも屈指の試験実績に基づく豊富な背景データを活用し、信頼性と再現性の高い評価が可能です。
ソリューション概要
Ames試験は、医薬品GLP(Good Laboratory Practice)に加え、不純物評価(ICH M7準拠)、労働安全衛生法GLP、化学物質審査規制法GLPにも対応して実施が可能です。また、染色体異常試験、培養細胞およびげっ歯類を用いた小核試験、マウスリンフォーマTK試験にも対応しています。
豊富な実績とGLP基準に準拠した体制で、信頼性を確保し、幅広い規制要件に対応した高品質なデータを提供します。
in vitro小核試験 実施例
ソリューションの特長
豊富な試験実績
GLP基準に準拠した試験と非GLP試験を合わせ、年間300~450件の試験を継続的に実施しています。この豊富な試験実績により、各試験系に対する高い習熟度を維持しています。また、継続的な精度管理と品質保証体制の強化により、再現性と信頼性の高いデータを安定的に提供しています。
迅速かつ少量の初期スクリーニング
少量の被験物質でも対応可能な設計により、前臨床段階での迅速な評価に最適です。経験豊富な技術スタッフが、信頼性の高い初期データを短期間で取得し、開発初期の意思決定を力強く支援します。
主な試験
- 不純物(ガイドラインM7準拠)のAmes試験
- 安衛法GLP(労働安全衛生規則第三十四条の三第二項の規定に基づく試験施設等が具備すべき基準)、化審法GLP(OECD-GLP原則に準拠したGLP制度)のAmes試験
- スクリーニング試験
- 5菌法、2菌法
- 用量設定および本試験、本試験のみで実施可能
- 複数の化合物を1試験にまとめて実施可能
- 培養細胞 (CHL/IU) を用いる染色体異常試験
- マウスリンフォーマTK試験
- 培養細胞 (CHL/IU、TK6) を用いる小核試験
- ラット/マウスを用いる小核試験
- Enhanced Ames test(EAT)
ソリューションに関するお問い合わせ
シミックは、さまざまな課題に対し、総合力を活かした幅広いソリューションを提供しています。
課題解決に向けて、各領域のエキスパートがお客さまのお問い合わせに対応します。
資料
関連情報
- 毒性試験
- 遺伝毒性試験
- 安全性薬理試験
- 医療機器の非臨床試験
- 再生医療等製品の非臨床試験